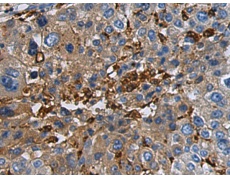
一抗

Background:
The gamma-aminobutyric acid (GABA) A receptor is a multisubunit chloride channel that mediates the fastest inhibitory synaptic transmission in the central nervous system. This gene encodes GABA A receptor, beta 1 subunit. It is mapped to chromosome 4p12 in a cluster comprised of genes encoding alpha 4, alpha 2 and gamma 1 subunits of the GABA A receptor. Alteration of this gene is implicated in the pathogenetics of schizophrenia.
Applications:
ELISA, IHC
Name of antibody:
GABRB1
Immunogen:
Synthetic peptide of human GABRB1
Full name:
gamma-aminobutyric acid type A receptor beta1 subunit
Synonyms:
EIEE45
SwissProt:
P18505
ELISA Recommended dilution:
5000-10000
IHC positive control:
Human liver cancer and Human prostate cancer
IHC Recommend dilution:
50-200


 購(gòu)物車(chē)
購(gòu)物車(chē) 幫助
幫助
 021-54845833/15800441009
021-54845833/15800441009